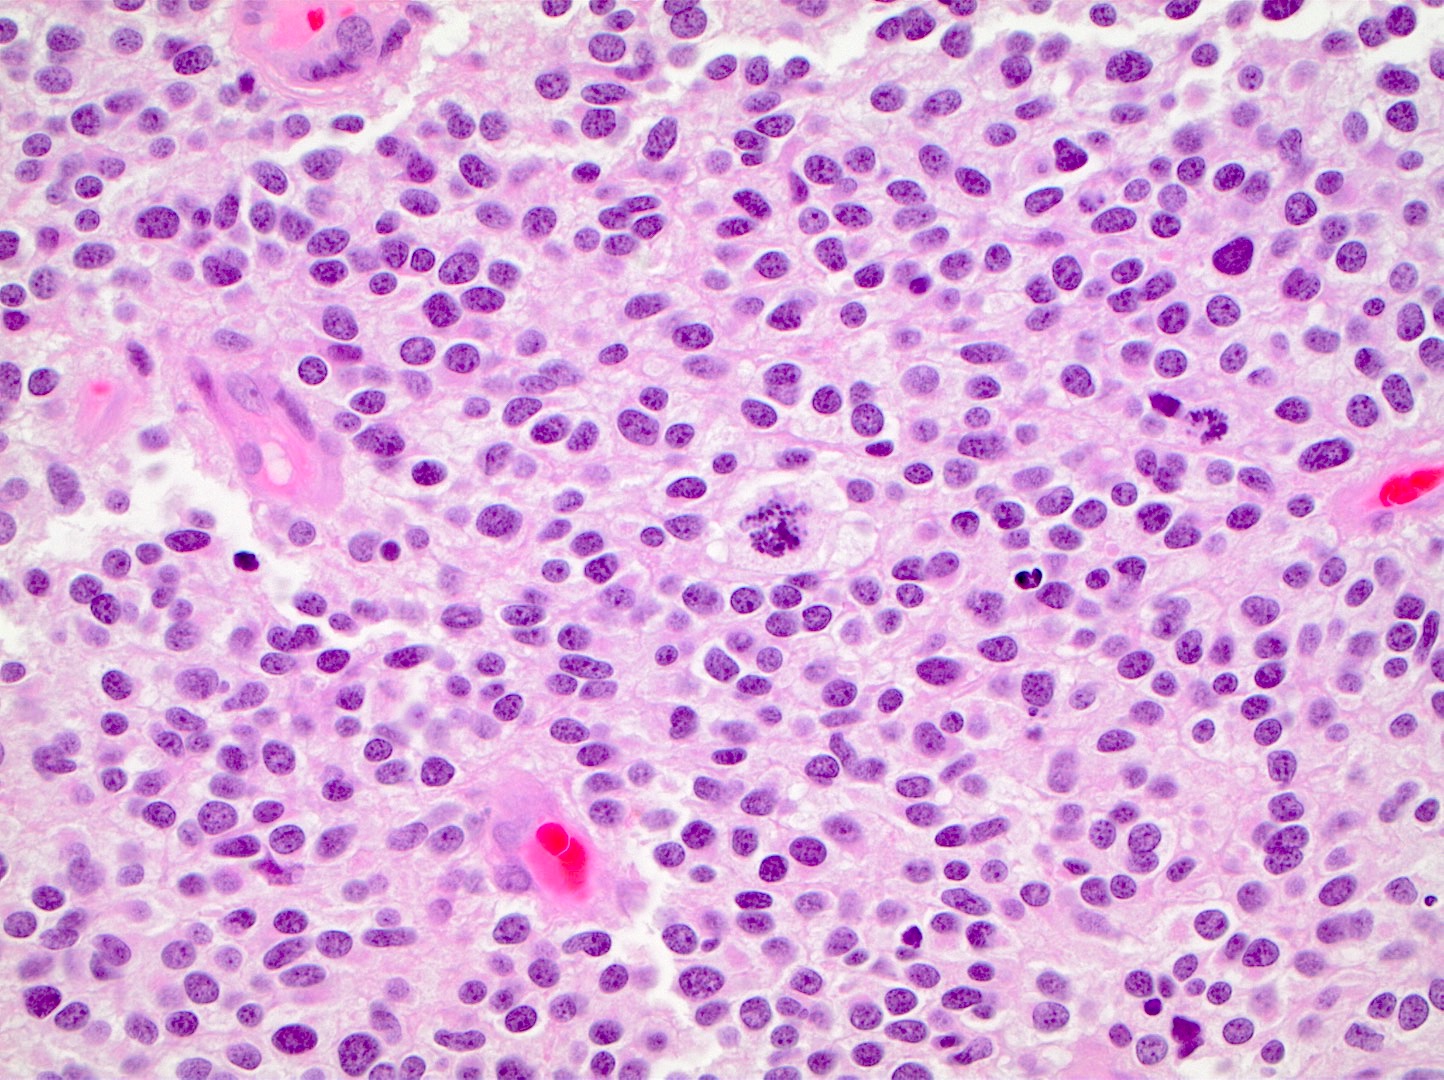

Table of Contents
Definition / general | Essential features | ICD coding | Epidemiology | Sites | Pathophysiology | Etiology | Clinical features | Grading | Diagnosis | Radiology description | Radiology images | Prognostic factors | Case reports | Treatment | Gross description | Frozen section description | Intraoperative frozen / smear cytology images | Microscopic (histologic) description | Microscopic (histologic) images | Virtual slides | Positive stains | Negative stains | Electron microscopy description | Molecular / cytogenetics description | Sample pathology report | Differential diagnosis | Additional references | Practice question #1 | Practice answer #1 | Practice question #2 | Practice answer #2Cite this page: Ahrendsen JT, Alexandrescu S. Oligodendroglioma, IDH mutant and 1p / 19q codeleted. PathologyOutlines.com website. https://www.pathologyoutlines.com/topic/cnstumoroligodendrogliomaidhmutant.html. Accessed September 15th, 2025.
Definition / general
- CNS WHO 2021 definition: diffusely infiltrating glioma with IDH1 or IDH2 mutation and codeletion of chromosome arms 1p and 19q (CNS WHO grade 2 or 3)
Essential features
- Diffusely infiltrating glial neoplasm with IDH1 or IDH2 mutation and 1p / 19q whole arm codeletion (both features are required for diagnosis)
- Morphology resembles nonneoplastic oligodendrocytes with round monotonous nuclei and perinuclear halos
- Chicken wire vasculature, microcalcifications and microcysts are characteristic (Neuro Oncol 2014;16:1244)
- Astrocytic differentiation does not preclude diagnosis if molecular features are present
- Small gemistocytes (mini gemistocytes) with rounded bellies of eosinophilic, eccentrically placed cytoplasm are occasionally seen, especially in grade 3 tumors (Acta Neuropathol 1984;64:265)
- Presence of other atypical features (including multinucleated giant cells, sarcomatous features, neurocytic differentiation or ganglion-like cells) does not preclude a diagnosis of oligodendroglioma if the requisite molecular features are present (Acta Neuropathol 2010;120:237, J Neuropathol Exp Neurol 2002;61:947, Neuropathology 2014;34:323)
Epidemiology
- Most epidemiologic data is based on histologic, rather than molecular, classification of oligodendroglioma
- Incidence of 0.23 cases per 100,000 population in the United States (Neuro Oncol 2019;21:v1)
- Incidence of CNS WHO grade 3 oligodendroglioma is 0.11
- Of all brain tumors in the United States:
- 0.9% are oligodendroglioma WHO grade 2
- 0.4% are oligodendroglioma WHO grade 3
- Peak incidence in fourth and fifth decades of life (Neuro Oncol 2020;22:iv1)
- Rare in infants and children (Am J Surg Pathol 2014;38:1058)
- Slight male predominance (Neuro Oncol 2019;21:v1)
Sites
- Infiltrative neoplasm involving the white and gray matter
- Can occur anywhere in the neuraxis; most common locations (Neuro Oncol 2020;22:iv1):
- Frontal lobes: 59%
- Temporal lobes: 14%
- Parietal lobes: 10%
- Occipital lobes: 1%
- Rarely observed in midline structures, brainstem, cerebellum or spinal cord
- Leptomeningeal spread occasionally observed, particularly at recurrence (Neurology 2019;92:e2483)
Pathophysiology
- Cell (or cells) of origin for oligodendroglioma remains unknown
- IDH mutation is likely the initiating event (driver mutation), which precedes 1p / 19q codeletion (Adv Anat Pathol 2015;22:50, Biomed Res Int 2014;2014:540236)
- IDH mutations give rise to metabolic alterations, with increased production of 2-hydroxyglutarate (2HG)
- Increased 2HG inhibits histone demethylation, causing a hypermethylation phenotype in neoplastic cells: glioma CpG island methylated phenotype (G CIMP) (Nature 2012;483:479, Acta Neuropathol 2013;125:621)
Etiology
- Generally sporadic without significant known risk factors
- Rare instances of familial oligodendroglioma and genetic alterations with associated increased risk of developing oligodendroglioma (Neuro Oncol 2018;20:1625, Cancer 2005;103:2363, J Natl Cancer Inst 2014;107:384)
Clinical features
- About 67% of patients present with seizure (PLoS One 2017;12:e0188419, Nat Rev Neurol 2017;13:340)
- Other common presenting symptoms: headache, focal neurologic deficits or cognitive / mental status change, depending on anatomic location
Grading
- WHO grade 2:
- Well differentiated tumor lacking anaplastic features (brisk mitotic activity, microvascular proliferation, necrosis)
- WHO grade 3:
- Prominent anaplastic features (necrosis, microvascular proliferation or brisk mitotic activity) are compatible with anaplastic oligodendroglioma, IDH mutant and 1p / 19q codeleted, WHO grade 3
- Strict mitotic activity criteria do not currently exist
- Some authors suggest ≥ 6 mitotic figures per 10 high power fields in resection specimens for grade 3 designation (J Neuropathol Exp Neurol 2001;60:248)
- Fewer mitotic figures might be sufficient for grade 3 designation in small biopsy specimens if other anaplastic features (vascular proliferation or necrosis) or significant nuclear atypia are present
- CDKN2A homozygous deletion may serve as a molecular marker of CNS WHO grade 3 in IDH mutant and 1p / 19q codeleted oligodendrogliomas (Neuro Oncol 2019;21:1519)
Diagnosis
- Magnetic resonance imaging (MRI), followed by stereotactic brain biopsy or surgical resection
- Methods to detect IDH gene mutation:
- Immunohistochemistry for IDH1 R132H (positive in > 90% of tumors) (Acta Neuropathol 2009;118:599)
- IDH2 mutations overrepresented in oligodendrogliomas compared with astrocytomas (Biomed Res Int 2014;2014:540236)
- Sanger sequencing
- Droplet digital polymerase chain reaction (ddPCR)
- Next generation sequencing
- MRI techniques to detect 2-hydroxyglutarate and therefore IDH mutation are under investigation (J Clin Invest 2013;123:3659)
- Immunohistochemistry for IDH1 R132H (positive in > 90% of tumors) (Acta Neuropathol 2009;118:599)
- Methods to detect 1p / 19q codeletion:
- Fluorescent in situ hybridization (FISH)
- Array comparative genomic hybridization
- Polymerase chain reaction (PCR)
Radiology description
- Computed topography (CT):
- Mixed density (hypodense and isodense) located in cortex or subcortical white matter (Radiology 2017;284:316)
- High attenuation areas, likely from calcifications
- MRI:
- Heterogeneous on T1 and T2 weighted imaging
- Typically no diffusion restriction
- Poorly circumscribed borders (AJNR Am J Neuroradiol 2017;38:678)
- Cystic changes are relatively common (Radiology 2017;284:316)
- Contrast enhancement present in < 20% of WHO grade 2 tumors and > 70% of WHO grade 3 tumors (AJNR Am J Neuroradiol 2012;33:852, Eur J Cancer 2019;107:15)
- Elevated 2HG by magnetic resonance spectroscopy could serve as radiologic surrogate of IDH mutation status (Nat Med 2012;18:624)
Radiology images
Prognostic factors
- Slow growing and relatively long overall survival
- Median overall survival: 11.6 years; 10 year overall survival rate: 51 - 63% (J Neuropathol Exp Neurol 2005;64:479, Neuro Oncol 2020;22:iv1)
- Longer median survival compared with grade 2 IDH mutant astrocytoma (median overall survival: 10.9 years) (Acta Neuropathol 2015;129:867)
- Favorable features (Crit Rev Oncol Hematol 2008;66:262):
- Younger age at diagnosis
- Tumor location in frontal lobe
- Presentation with seizures
- Macroscopically complete surgical resection
- CNS WHO grade 2 histology
- Higher postoperative Karnofsky score
- Unfavorable features:
- Contrast enhancement on MRI
- CNS WHO grade 3 histology (Eur J Cancer 2020;137:10, Oncotarget 2014;5:1515)
- CDKN2A / CDKN2B homozygous deletion (J Neuropathol Exp Neurol 2004;63:314, Neuro Oncol 2019;21:1519)
- Local recurrence and malignant transformation are common
Case reports
- 26 year old man presents with nausea, headache and rash (JAAD Case Rep 2019;6:1)
- 43 year old woman with headaches, blurry vision and a right parietal mass (Front Neurol 2018;9:700)
- 44 year old man with sudden right sided optic neuritis (BMJ Case Rep 2018;2018:bcr2018225318)
- 48 year old man presents with seizures (Front Oncol 2021;10:601452)
- 55 year old man with mass lesion in the superior left temporal gyrus (Brain Pathol 2019;29:693)
Treatment
- Gross total resection, if possible
- Adjuvant chemotherapy (temozolomide) and radiotherapy
- Given to patients with symptomatic or progressive tumors, tumors with CNS WHO grade 3 histology or those with large postoperative residual tumor
- References: Crit Rev Oncol Hematol 2008;66:262, Lancet 2005;366:985
Gross description
- Variably well defined, gray-pink mass
- Mucoid change can give a gelatinous consistency
- Areas of cystic degeneration, calcifications, hemorrhage or necrosis can be seen
Frozen section description
- Moderately cellular, diffusely infiltrating neoplasm
- Glia with mild to moderate nuclear atypia
- Round nuclei with speckled chromatin
- Calcifications, perineuronal satellitosis or perivascular accumulation of tumor cells may be seen
- Will not see perinuclear halos on frozen section or smear preparations
- Anaplastic features (necrosis, vascular proliferation, mitoses) may be seen in WHO grade 3 tumors
- Reference: J Cytol 2011;28:147
Intraoperative frozen / smear cytology images
Microscopic (histologic) description
- Closely packed cells with small, round, monotonous nuclei (slightly larger than a normal oligodendrocyte)
- Perinuclear clearing (fried egg appearance)
- Formalin fixation artifact
- Will not be seen on frozen sections or smear preparations
- Network of thin walled, branching blood vessels (chicken wire vasculature)
- Microcalcifications (calcospherites) are characteristic
- Presence of perineural, perivascular or subpial aggregates of tumor cells (secondary structures of Scherer)
- Occasional mitoses and moderate nuclear atypia are still consistent with grade 2 designation (J Neuropathol Exp Neurol 2001;60:248)
- Not uncommon to find well differentiated / fibrillary astrocytic morphology (Acta Neuropathol 1984;64:265)
- Features of CNS WHO grade 3 oligodendroglioma:
- Presence of microvascular proliferation
- Presence of necrosis
- Presence of brisk mitotic activity
- Strict mitotic figure cutoffs do not currently exist; some authors suggest ≥ 6 mitoses per 10 high power fields for WHO grade 3 designation in tumors without necrosis or vascular proliferation (Neuro Oncol 2014;16:1244, Neuro Oncol 2016;18:888)
Microscopic (histologic) images
Contributed by Jared T. Ahrendsen, M.D., Ph.D. and John DeWitt, M.D., Ph.D.
Virtual slides
Positive stains
- IDH1 (R132H)
- Positive in > 90% of oligodendrogliomas (Acta Neuropathol 2009;118:599)
- Negative staining is not incompatible with oligodendroglioma if 1p / 19q codeletion is present
- Olig2, GFAP
- ATRX (retained; wildtype pattern)
- p53 (weak staining in rare cells; wildtype staining pattern)
- Ki67:
- Grade 2 tumors: usually < 5% of tumor nuclei
- Grade 3 tumors: generally > 10% of tumor nuclei (Neuro Oncol 2014;16:1244, Neuro Oncol 2016;18:888)
- Trio of IDH1 (R132H), ATRX and p53 is useful to distinguish oligodendroglioma from IDH mutant astrocytoma (Acta Neuropathol 2012;124:615)
Negative stains
- Loss of H3K27 trimethylation (Acta Neuropathol 2020;139:597)
- Keratins (although certain cytokeratin cocktails may demonstrate crossreactivity)
Electron microscopy description
- Not routinely used for diagnostic purposes
Molecular / cytogenetics description
- Oligodendroglioma is a molecularly defined diagnosis requiring demonstration of both:
- IDH1 or IDH2 mutation
- Unbalanced translocation between chromosome 1 and 19, resulting in whole arm loss of 1p and 19q chromosomal material (1p / 19q codeletion)
- Incomplete or partial deletions are not compatible with oligodendroglioma diagnosis
- Other common molecular alterations:
- TERT promotor mutation in vast majority (Nat Genet 2015;47:458)
- Early (clonal) event in tumorogenesis (Oncotarget 2019;10:3641)
- Often absent in teenagers with oligodendroglioma (Acta Neuropathol Commun 2018;6:95)
- CIC mutation in 70% (N Engl J Med 2015;372:2499)
- FUBP1 mutations in 20 - 30% (Science 2011;333:1453)
- NOTCH1 mutation in 15% (Nat Genet 2015;47:458)
- Loss of H3K27 trimethylation by immunohistochemistry (Acta Neuropathol 2020;139:597)
- TERT promotor mutation in vast majority (Nat Genet 2015;47:458)
- Molecular alterations associated with tumor progression:
- Increased copy number alterations (Neuro Oncol 2018;20:66)
- CDKN2A / CDKN2B deletions on chromosome 9p21 (PLoS One 2016;11:e0168728)
- PIK3CA mutation (Clin Cancer Res 2019;25:4375)
- TCF12 mutation (Nat Commun 2015;6:7207)
- MYC amplification (Nat Commun 2016;7:11263)
- Epigenetic changes:
- Glioma CpG island methylator phenotype (G CIMP) (Cancer Cell 2010;17:510)
- MGMT promotor methylation is detectable in the majority of tumors (Int J Cancer 2005;113:379)
Sample pathology report
- Brain, frontal lobe, left, tumor, resection:
- Integrated diagnosis: oligodendroglioma, IDH1 R132H mutant and 1p / 19q codeleted
- Histologic diagnosis: oligodendroglioma
- CNS WHO grade: 3
- Molecular information:
- IDH1 R132H mutation
- 1p / 19q codeletion
- TERT promotor mutation
Differential diagnosis
- Astrocytoma, IDH mutant:
- Other tumors with oligo-like morphology:
- Dysembryoplastic neuroepithelial tumor (DNET)
- Central neurocytoma
- Polymorphous low grade neuroepithelial tumor of the young (PLNTY)
- Clear cell ependymoma
- Metastatic clear cell carcinomas
- These tumors lack IDH mutations and 1p / 19q codeletion and are generally circumscribed instead of infiltrative
- Macrophage rich lesions:
- Stain positive with macrophage markers
Additional references
Practice question #1
A 42 year old man presents to the emergency room with new onset seizures. Brain magnetic resonance imaging (MRI) reveals a nonenhancing infiltrative mass lesion in the right frontal lobe. A biopsy is performed, shown in the image above. What molecular features are most likely present?
- BRAF V600E mutation
- EGFR amplification
- IDH mutation and 1p / 19q codeletion
- IDH, p53 and ATRX mutations
- Polysomy 7 and monosomy 10 (+7 / -10)
Practice answer #1
C. IDH mutation and 1p / 19q codeletion. The image shows an oligodendroglioma, which is defined by the presence of IDH mutation and 1p / 19q codeletion.
Comment Here
Reference: Oligodendroglioma, IDH mutant and 1p / 19q codeleted
Comment Here
Reference: Oligodendroglioma, IDH mutant and 1p / 19q codeleted
Practice question #2
Which of the following is a common genetic alteration in oligodendroglioma, IDH mutant and 1p / 19q codeleted?
- ATRX mutation
- BRAF V600E
- EGFR amplification
- p53 mutation
- TERT promotor mutation
Practice answer #2
E. TERT promotor mutation. TERT promotor mutations are commonly observed in oligodendroglioma.
Comment Here
Reference: Oligodendroglioma, IDH mutant and 1p / 19q codeleted
Comment Here
Reference: Oligodendroglioma, IDH mutant and 1p / 19q codeleted